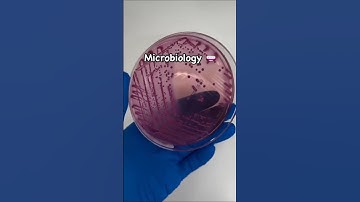
Microbiology #laboratory #science #laboratorytechniques #lab #biotech #microbiology

⬇ DOWNLOAD NOW
Kalau muncul iklan pop-up, tutup lalu klik tombol kembali
Download lagu Scientific Precision: Inside Our Custom Microbiology Lab Design secara gratis hanya untuk keperluan promosi. Dukung artis favorit kamu dengan membeli musik original di iTunes atau platform resmi lainnya.
 microbiology 🧫 #laboratory #science #medlab #lab #scientificjourney #microbiology #shorts
microbiology 🧫 #laboratory #science #medlab #lab #scientificjourney #microbiology #shorts
 microbiology #laboratory #medlab #science #scientificjourney #lab #microbiology #shorts
microbiology #laboratory #medlab #science #scientificjourney #lab #microbiology #shorts
 microbiology #laboratory #science #scientificjourney #lab #research #researchlab #shorts #viralvideo
microbiology #laboratory #science #scientificjourney #lab #research #researchlab #shorts #viralvideo
 Inside My Microbiology Laboratory #microbiology #shorts
Inside My Microbiology Laboratory #microbiology #shorts
 Microbiology 🦠 #laboratory #science #laboratorytechniques #labtechnition #lab #microbiology #shorts
Microbiology 🦠 #laboratory #science #laboratorytechniques #labtechnition #lab #microbiology #shorts
Microbiology #laboratory #science #laboratorytechniques #lab #biotech #microbiology
Microbiology #laboratory #science #laboratorytechniques #lab #biotech #microbiology
 🔬 Inside ITECH’s Microbiology Lab | Filmed by Momento Digital | #Shorts
🔬 Inside ITECH’s Microbiology Lab | Filmed by Momento Digital | #Shorts
 #Microbiology Lab #MicrobeMasters #GermBusters# LabLife #MicroscopicWonders #Infectious #shorts
#Microbiology Lab #MicrobeMasters #GermBusters# LabLife #MicroscopicWonders #Infectious #shorts